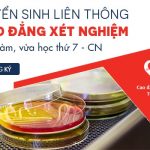

TRƯỜNG CAO ĐẲNG DƯỢC SÀI GÒN
▹ Cơ sở đào tạo TP Hồ Chí Minh: 215E+D Nơ Trang Long, Phường 12, Quận Bình Thạnh, TP Hồ Chí Minh. Điện thoại: 1800 1201
▹ Cơ sở đào tạo tại TP Nam Định: Đường Cầu Đông, Phường Lộc Vượng, TP Nam Định, Tỉnh Nam Định. Điện thoại: 0825.022.022
▹ Cơ sở đào tạo tại Long An: Ấp 8, Xã Lương Hoà, Huyện Bến Lức, Tỉnh Long An
▹ Tư vấn tuyển sinh 24/7: Zalo: 07.6981.6981